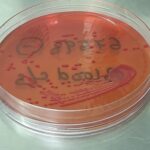
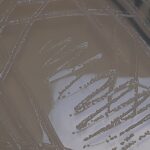

Tag: Culture and sensitivity testing
Synovial Fluid Culture and Sensitivity Test-Introduction, Report, Clinical Significance, Common Pathogens, and Keynotes
 Introduction A Synovial Fluid Culture and Sensitivity Test is a...
Introduction A Synovial Fluid Culture and Sensitivity Test is a...
CVP Line Culture and Sensitivity Test-Introduction, Report, Clinical Significance, Common Pathogens, and Keynotes
Introduction of CVP Line Culture and Sensitivity Test- The CVP Line...
Introduction of CVP Line Culture and Sensitivity Test- The CVP Line...
Serratia liquefaciens: Introduction, Morphology, Pathogenicity, Lab Diagnosis, Treatment, Prevention, and Keynotes
Introduction Serratia liquefaciens is a Gram-negative bacterium that belongs to...
Introduction Serratia liquefaciens is a Gram-negative bacterium that belongs to...
